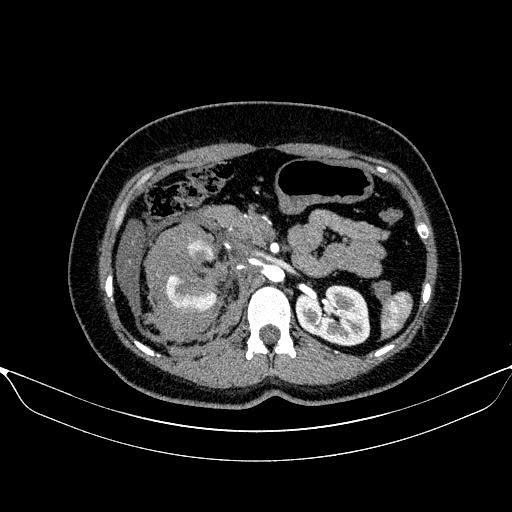

ĐĂNG KÝ THÀNH CÔNG
Bộ phận CSKH sẽ phản hồi bạn trong thời gian sớm nhất
Số 9, đường Trần Bình, phường Từ Liêm, TP Hà Nội
Ngày 14/2/2026, ngày đầu tiên trong kỳ nghỉ Tết kéo dài, Khoa Cấp cứu Bệnh viện 19-8 tiếp nhận bệnh nhân P.T.N.L (24 tuổi) trong tình trạng mệt mỏi, đau bụng nhiều, kèm xây xát vùng mặt – trán do tai nạn giao thông.
Ngay sau khi nhập viện, bệnh nhân được thăm khám khẩn trương và chỉ định thực hiện siêu âm ổ bụng, chụp CT sọ não và CT bụng có tiêm thuốc cản quang. Kết quả chẩn đoán hình ảnh cho thấy bệnh nhân bị vỡ thận phải độ IV theo phân loại AAST 2018 – một tổn thương nặng, có nguy cơ cao phải cắt bỏ thận nếu không được xử trí kịp thời.
Trước tình huống cấp cứu phức tạp trong thời điểm đặc biệt – ngày đầu kỳ nghỉ Tết, kíp trực cấp cứu đã lập tức mời hội chẩn khẩn cấp giữa Khoa Chẩn đoán hình ảnh & Y học hạt nhân và Khoa Ngoại tiết niệu. Sau khi đánh giá toàn diện tình trạng lâm sàng và hình ảnh học, các bác sỹ thống nhất lựa chọn phương pháp can thiệp nội mạch chọn lọc nút mạch cầm máu nhằm bảo tồn tối đa chức năng thận cho bệnh nhân thay vì phải phẫu thuật cắt thận như trước đây.

Ca can thiệp được ThS.BSCKII Lê Hồng Kỳ - trưởng khoa chẩn đoán hình ảnh và y học hạt nhân trực tiếp thực hiện. Trong quá trình can thiệp, chụp động mạch thận phải ghi nhận hình ảnh thoát thuốc từ các nhánh động mạch cực dưới. Bác sĩ tiến hành kỹ thuật siêu chọn lọc bằng microcatheter và nút mạch cầm máu bằng hỗn dịch Histoacryl – Lipiodol kết hợp Spongel.

Chụp kiểm tra sau nút mạch cho thấy các nhánh mạch tổn thương đã được tắc hoàn toàn, nhu mô thận còn lại được bảo tồn tốt. Thủ thuật diễn ra an toàn, không ghi nhận biến chứng trong và ngay sau can thiệp. Sau can thiệp, bệnh nhân được chuyển về theo dõi và điều trị tại khoa ngoại tiết niệu, hiện tình trạng bệnh nhân ổn định, tuy nhiên vẫn cần được theo dõi sát diễn biến bệnh.
Ca can thiệp thành công không chỉ giúp giữ lại được quả thận cho cô gái trẻ mà còn khẳng định năng lực triển khai kỹ thuật can thiệp mạch hiện đại, sự phối hợp hiệu quả đa chuyên khoa và tinh thần sẵn sàng trực chiến vì người bệnh của đội ngũ y bác sĩ Bệnh viện 19-8 trong những ngày Tết Nguyên đán.
_BS Phạm Thị Quỳnh Anh- Khoa CĐHA&YHHN_